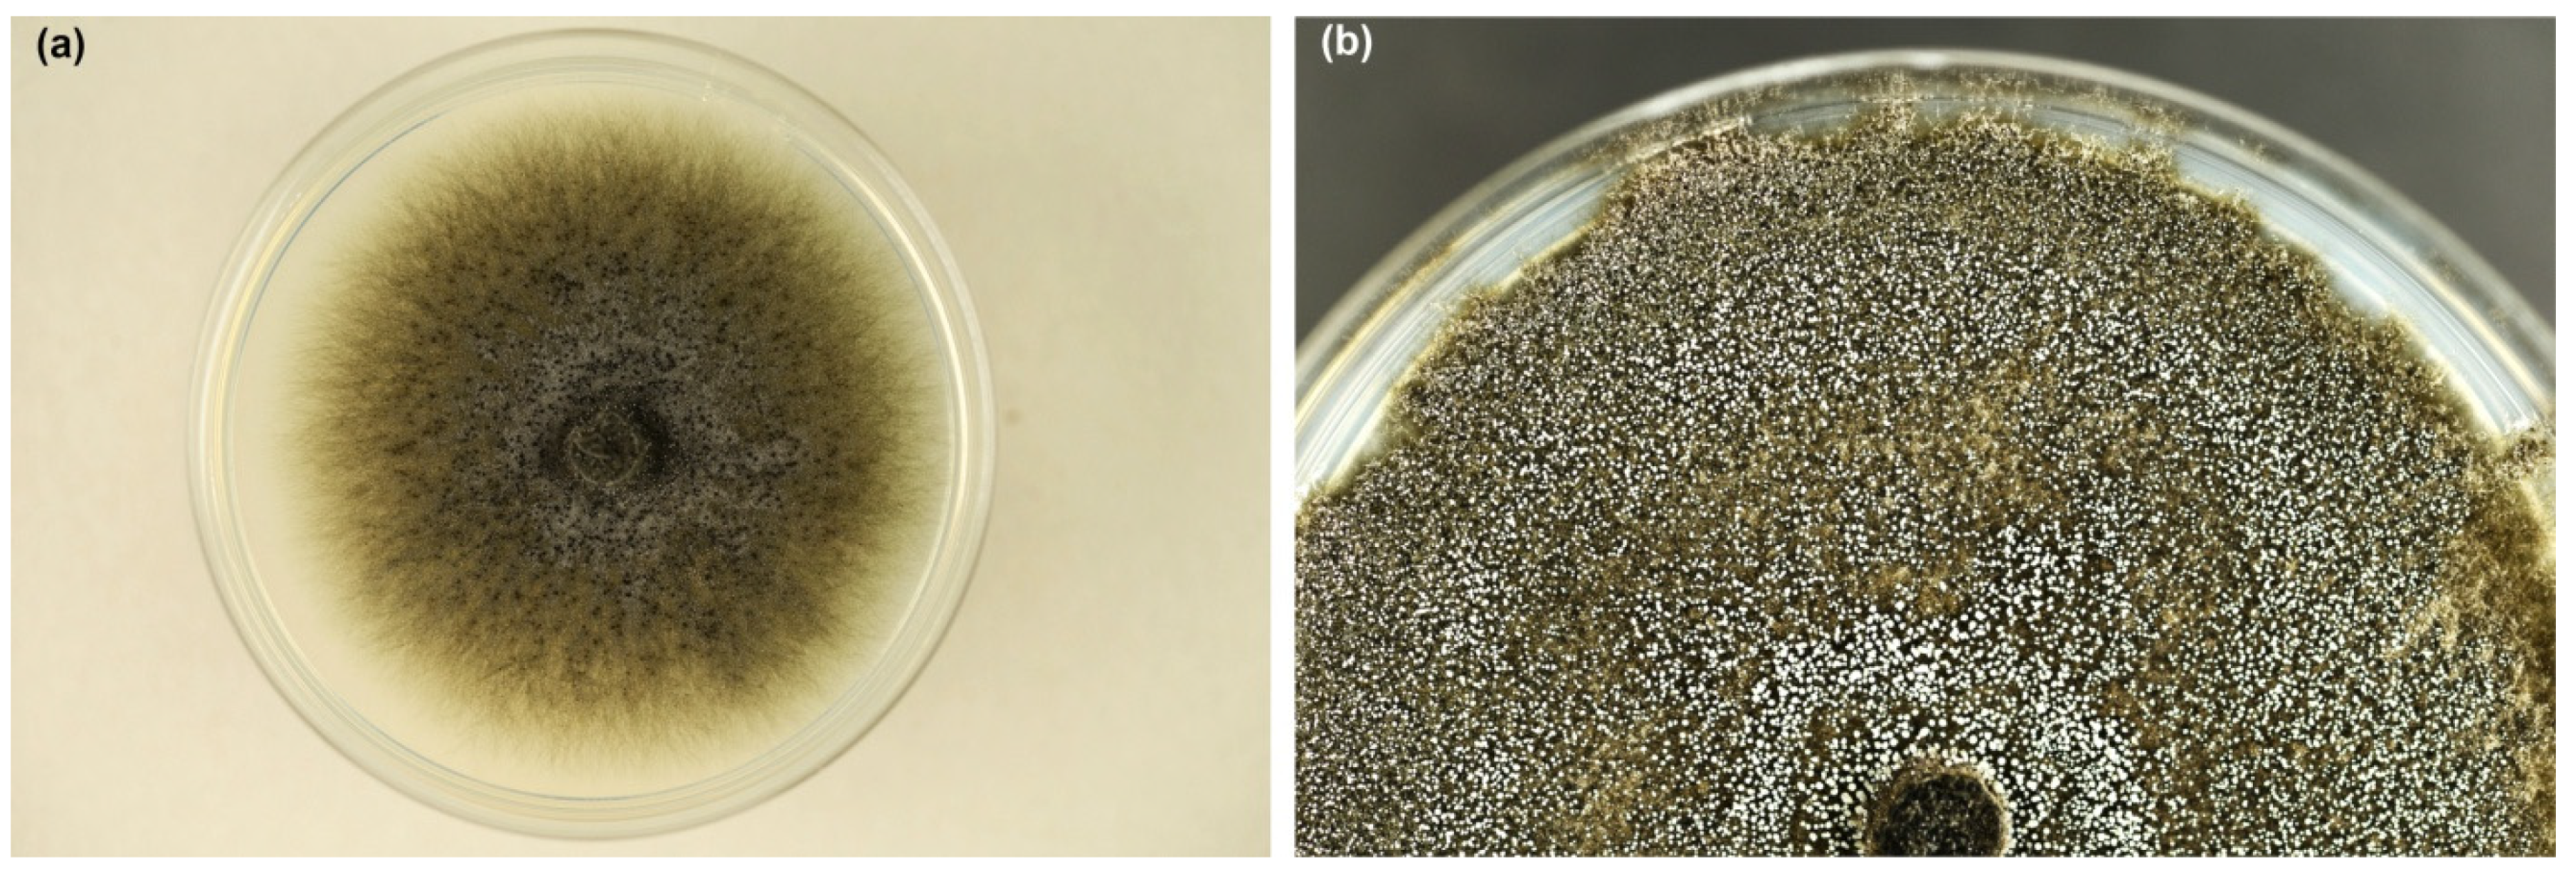
Jof 10 00465 g003 Jof 10 00465 g003

Recognition of Davidsoniella virescens on Fagus sylvatica Wood in Poland and Assessment of Its Pathogenicity
Abstract
1. Introduction
2. Materials and Methods
2.1. Study Material, Isolation and Microscopic Analyses
2.2. DNA Extraction, PCR, Sequencing and Phylogenetic Analyses
2.3. Colony Growth in Relation to Temperature
2.4. Pathogenicity Test
2.5. Statistical Analyses
3. Results
3.1. Symptoms on Fagus sylvatica Logs In Situ
3.2. Morphological Characterization of Davidsoniella virescens
3.2.1. In Vitro
3.2.2. In Situ
3.3. DNA Sequence Data and Phylogenetic Analysis
3.4. Colony Growth in Relation to Temperature
3.5. Pathogenicity Test
3.5.1. Fagus sylvatica
3.5.2. Acer saccharum
3.5.3. Re-Isolation and Control
4. Discussion
4.1. Morphological, Phylogenetic and Physiological Aspects
4.2. Pathogenicity of D. virescens Isolates from F. sylvatica
5. Conclusions
Supplementary Materials
Author Contributions
Funding
Institutional Review Board Statement
Informed Consent Statement
Data Availability Statement
Acknowledgments
Conflicts of Interest
References
- de Beer, Z.W.; Duong, T.A.; Barnes, I.; Wingfield, B.D.; Wingfield, M.J. Redefining Ceratocystis and Allied Genera. Stud. Mycol. 2014, 79, 187–219. [Google Scholar] [CrossRef]
- Wingfield, B.D.; Barnes, I.; de Beer, Z.W.; De Vos, L.; Duong, T.A.; Kanzi, A.M.; Naidoo, K.; Nguyen, H.D.T.; Santana, Q.C.; Sayari, M.; et al. Draft Genome Sequences of Ceratocystis eucalypticola, Chrysoporthe cubensis, C. deuterocubensis, Davidsoniella virescens, Fusarium temperatum, Graphilbum fragrans, Penicillium nordicum, and Thielaviopsis musarum. IMA Fungus 2015, 6, 493–506. [Google Scholar] [CrossRef] [PubMed]
- Index Fungorum—Search Page. Available online: http://www.indexfungorum.org/names/Names.asp (accessed on 22 May 2024).
- Davidson, R.W. Two American Hardwood Species of Endoconidiophora Described as New. Mycologia 1944, 36, 300–306. [Google Scholar] [CrossRef]
- Münch, E. Die Blaufäule des Nadelholzes. Naturwissenschaftliche Z. Forst Landwirtsch. 1907, 5, 531–573. [Google Scholar]
- Bakshi, B.K. Fungi Associated with Ambrosia Beetles in Great Britain. Trans. Br. Mycol. Soc. 1950, 33, 111–120. [Google Scholar] [CrossRef]
- Bakshi, B.K. Studies on Four Species of Ceratocystis, with a Discussion of Fungi Causing Sap-Stain in Britain. Mycol. Pap. 1951, 35, 1–16. [Google Scholar]
- Moreau, C. Coexistence Des Formes Thielaviopsis et Graphium Chez Une Souche de Ceratocystis Major (van Beyma) Comb. Nov. Remarques Sur Les Variations Des Ceratocystis. Rev. Mycol. Supplément Colon. 1952, 17, 17–25. [Google Scholar]
- Hunt, J. Taxonomy of the Genus Ceratocystis. Lloydia 1956, 19, 1–59. [Google Scholar]
- Griffin, H.D. The Genus Ceratocystis in Ontario. Can. J. Bot. 1968, 46, 689–718. [Google Scholar] [CrossRef]
- Olchowecki, A.; Reid, J. Taxonomy of the Genus Ceratocystis in Manitoba. Can. J. Bot. 1974, 52, 1675–1711. [Google Scholar] [CrossRef]
- Upadhyay, H.P. A Monograph of Ceratocystis and Ceratocystiopsis; The University of Georgia Press: Athens, Greece, 1981. [Google Scholar]
- Nag Raj, T.R.; Kendrick, B. A Monograph of Chalara and Allied Genera; Wilfrid Laurier University Press: Waterloo, ON, Canada, 1975. [Google Scholar]
- Kile, G.; Walker, J. Chalara australis sp. Nov. (Hyphomycetes), a Vascular Pathogen of Nothofagus cunninghamii (Fagaceae) in Australia and Its Relationship to Other Chalara Species. Aust. J. Bot. 1987, 35, 1–32. [Google Scholar] [CrossRef]
- Birkinshaw, J.H.; Morgan, E.N. Biochemistry of Wood-Rotting Fungi. 6. Volatile Metabolic Products of Species of Endoconidiophora. Biochem. J. 1950, 47, 55–59. [Google Scholar] [CrossRef]
- Koch, W.-G.; Sinnwell, V. Isopulegol from Liquid Cultures of the Fungus Ceratocystis coerulescens (Ascomycotina). Z. Für Naturforsch. C 1987, 42, 159–161. [Google Scholar] [CrossRef]
- Hanssen, H.-P. Volatile Metabolites Produced by Species of Ophiostoma and Ceratocystis. In Ceratocystis and Ophiostoma: Taxonomy, Ecology and Pathogenicity; Wingfield, M.J., Seifert, K.A., Webber, J.F., Eds.; American Phytopathological Society Press: St. Paul, MN, USA, 1993; pp. 117–125. [Google Scholar]
- Harrington, T.C.; Steimel, J.P.; Wingfield, M.J.; Kile, G.A. Isozyme Variation and Species Delimitation in the Ceratocystis coerulescens Complex. Mycologia 1996, 88, 104. [Google Scholar] [CrossRef]
- Witthuhn, R.C.; Wingfield, B.D.; Wingfield, M.J.; Wolfaardt, M.; Harrington, T.C. Monophyly of the Conifer Species in the Ceratocystis coerulescens Complex Based on DNA Sequence Data. Mycologia 1998, 90, 96–101. [Google Scholar] [CrossRef]
- Witthuhn, R.C.; Harrington, T.C.; Steimel, J.P.; Wingfield, B.D.; Wingfield, M.J. Comparison of Isozymes, RDNA Spacer Regions and MAT-2 DNA Sequences as Phylogenetic Characters in the Analysis of the Ceratocystis coerulescens Complex. Mycologia 2000, 92, 447–452. [Google Scholar] [CrossRef]
- Montoya, M.M.; Wingfield, M.J. A Review of Ceratocystis Sensu Stricto with Special Reference to the Species Complexes C. coerulescens and C. fimbriata. Rev. Fac. Nal. Agr. Medellín 2006, 59, 3045–3075. [Google Scholar]
- Lagerberg, T. Biological and Practical Researches into Blueing in Pine and Spruce. Sven Skogsvardsforen Tidskr 1927, 25, 145–272. [Google Scholar]
- Houston, D.R. Recognizing and Managing Sapstreak Disease of Sugar Maple; Research Paper—Northeastern Forest Experiment Station; USDA Forest Service: Washington, DC, USA, 1993. [Google Scholar]
- Gionni, A.; Pecori, F.; Santini, A.; Camilleri, M. Pest Survey Card on Davidsoniella virescens. EFSA Support. Publ. 2023, 20, 8186E. [Google Scholar] [CrossRef]
- Sinclair, W.A.; Lyon, H.H. Diseases of Trees and Shrubs, 2nd ed.; Cornell University Press: Ithaca, NY, USA, 2005; ISBN 978-0-8014-4371-8. [Google Scholar]
- Webber, J. Abbreviated Pest Risk Analysis for Ceratocystis virescens. In Forest Research; 2018; pp. 1–8. Available online: https://planthealthportal.defra.gov.uk/pests-and-diseases/uk-plant-health-risk-register/downloadExternalPra.cfm?id=3513 (accessed on 19 May 2024).
- Hepting, G.H. Sapstreak, a New Killing Disease of Sugar Maple. Phytopathology 1944, 34, 1069–1076. [Google Scholar]
- Kessler, K.J.J. Sapstreak Disease of Sugar Maple. For. Pest Leafl. USDA For. Serv. 1972, 128, 1–4. [Google Scholar]
- Richter, D.L. The Sugar Maple Sapstreak Fungus (Ceratocystis virescens) (Davidson) Moreau, Ascomycota) in the Huron Mountains, Marquette County, Michigan. Mich. Bot. 2012, 51, 73–82. [Google Scholar]
- Kehr, R.; Pehl, L.; Wulf, A.; Schröder, T.; Kaminski, K. Zur Gefährdung von Bäumen und Waldökosystemen durch Eingeschleppte Krankheiten und Schädlinge. Nachrichtenblatt Dtsch. Pflanzenschutzdienstes 2004, 56, 217–238. [Google Scholar]
- Ohman, J.H.; Spike, A.B. Effect of Straining Caused by Sapstreak Disease on Sugar Maple Log and Lumber Values; Research Note NC-12; U.S. Dept. of Agriculture, Forest Service, North Central Forest Experiment Station: St. Paul, MN, USA, 1966; Volume 12, pp. 1–4. [Google Scholar]
- Mielke, M.E.; Charette, D.A. The Incidence of Sapstreak Disease of Sugar Maple in Menominee County, Wisconsin, and Its Relationship to Wounds and Season of Logging. North. J. Appl. For. 1989, 6, 65–67. [Google Scholar] [CrossRef]
- Smith, K.T. Sapstreak Disease and Biodeterioration of Sugar Maple. Biodeterior. Res. 1990, 3, 303–310. [Google Scholar]
- Bal, T.L.; Richter, D.L.; Storer, A.J.; Jurgensen, M.F. The Relationship of the Sapstreak Fungus, Ceratocystis virescens, to Sugar Maple Dieback and Decay in Northern Michigan. Am. J. Plant Sci. 2013, 04, 436–443. [Google Scholar] [CrossRef]
- EPPO Global Database. Available online: https://gd.eppo.int/ (accessed on 21 April 2024).
- Zajonc, V.J.; Wulf, A. European Maple Species Endangered by Sapstreak (Ceratocystis virescens)? Nachrichtenblatt Dtsch. Pflanzenschutzdienstes 1997, 49, 297–300. [Google Scholar]
- Kowalski, T.; Bilański, P.; Grad, B. The Occurrence of Apiognomonia hystrix and Its Pathogenicity towards Acer Pseudoplatanus and Fraxinus Excelsior under Field Conditions. Forests 2021, 13, 35. [Google Scholar] [CrossRef]
- Glass, N.L.; Donaldson, G.C. Development of Primer Sets Designed for Use with the PCR to Amplify Conserved Genes from Filamentous Ascomycetes. Appl. Environ. Microbiol. 1995, 61, 1323–1330. [Google Scholar] [CrossRef]
- Hausner, G.; Reid, J.; Klassen, G.R. On the Phylogeny of Ophiostoma, Ceratocystis s.s., and Microascus, and Relationships within Ophiostoma Based on Partial Ribosomal DNA Sequences. Can. J. Bot. 1993, 71, 1249–1265. [Google Scholar] [CrossRef]
- White, T.J.; Bruns, T.; Lee, S.; Taylor, J.W. Amplification and Direct Sequencing of Fungal Ribosomal RNA Genes for Phylogenetics. In PCR Protocols: A Guide to Methods and Applications; Innis, M.A., Gelfand, D.H., Sninsky, J.J., White, T.J., Eds.; Academic Press Inc.: New York, NY, USA, 1990; pp. 315–322. [Google Scholar]
- Rehner, S.A.; Samuels, G.J. Taxonomy and Phylogeny of Gliocladium Analysed from Nuclear Large Subunit Ribosomal DNA Sequences. Mycol. Res. 1994, 98, 625–634. [Google Scholar] [CrossRef]
- Vilgalys, R.; Hester, M. Rapid Genetic Identification and Mapping of Enzymatically Amplified Ribosomal DNA from Several Cryptococcus Species. J. Bacteriol. 1990, 172, 4238–4246. [Google Scholar] [CrossRef]
- Oliveira, L.S.S.; Harrington, T.C.; Ferreira, M.A.; Damacena, M.B.; Al-Sadi, A.M.; Al-Mahmooli, I.H.S.; Alfenas, A.C. Species or Genotypes? Reassessment of Four Recently Described Species of the Ceratocystis Wilt Pathogen, Ceratocystis fimbriata, on Mangifera indica. Phytopathology 2015, 105, 1229–1244. [Google Scholar] [CrossRef] [PubMed]
- Altschul, S.F.; Gish, W.; Miller, W.; Myers, E.W.; Lipman, D.J. Basic Local Alignment Search Tool. J. Mol. Biol. 1990, 215, 403–410. [Google Scholar] [CrossRef] [PubMed]
- Kowalski, T.; Bilański, P.; Kraj, W. Pathogenicity of Fungi Associated with Ash Dieback towards Fraxinus excelsior. Plant Pathol. 2017, 66, 1228–1238. [Google Scholar] [CrossRef]
- TIBCO Software Inc. Data Science Workbench. Statistica, Version 13.1; TIBCO Software Inc.: Palo Alto, CA, USA, 2020. Available online: https://tibco.com (accessed on 1 May 2024).
- Jeger, M.; Bragard, C.; Caffier, D.; Candresse, T.; Chatzivassiliou, E.; Dehnen-Schmutz, K.; Gilioli, G.; Gregoire, J.; Jaques Miret, J.A.; MacLeod, A.; et al. Pest Categorisation of Davidsoniella virescens. EFSA J. 2017, 15, e05104. [Google Scholar] [CrossRef]
- Shigo, A.L. Observations on the Succession of Fungi on Hardwood Pulpwood Bolts. Plant Dis. Rep. 1962, 46, 379–380. [Google Scholar]
- Ohman, J.H.; Kessler, K.J. Current Status of the Sapstreak Disease of Sugar Maple in the Lake States; Research Note LS-10; Lake States Forest Experiment Station, U.S. Dept. of Agriculture: St. Paul, MN, USA, 1963; Volume 11, pp. 1–4. [Google Scholar]
- Juzwik, J.; Appel, D.N.; MacDonald, W.L.; Burks, S. Challenges and Successes in Managing Oak Wilt in the United States. Plant Dis. 2011, 95, 888–900. [Google Scholar] [CrossRef] [PubMed]
- Harrington, T.C. Ceratocystis Diseases. In Infectious Forest Diseases; Gonthier, P., Nicolotti, G., Eds.; CABI: Wallingford, UK, 2013; pp. 230–255. [Google Scholar]
- Jankowiak, R.; Bilański, P. Ophiostomatoid Fungi Associated with Root-feeding Bark Beetles on Scots Pine in Poland. For. Pathol. 2013, 43, 422–428. [Google Scholar] [CrossRef]
- Walters, J.W. Sapstreak Disease of Sugar Maple. In Northern Hardwood Notes; U.S. Department of Agriculture, Forest Service, North Central Research Station: St. Paul, MN, USA, 1992. [Google Scholar]
- Harrington, T.C.; Steimel, J.; Kile, G. Genetic Variation in Three Ceratocystis Species with Outcrossing, Selfing and Asexual Reproductive Strategies. Eur. J. For. Pathol. 1998, 28, 217–226. [Google Scholar] [CrossRef]
- Harrington, T.C. The Genus Ceratocystis: Where Does the Oak Wilt Fungus Fit? In Proceedings of the 2nd National Oak Wilt Symposium; Appel, D.N., Billings, R.F., Eds.; USDA Forest Service, Forest Health Protection: St. Paul, MN, USA, 2009; pp. 27–42. [Google Scholar]
- Collins, R.P.; Morgan, M.E. Identity of Fruit-like Aroma Substances Synthesized by Endoconidial-Forming Fungi. Phytopathology 1962, 52, 407–409. [Google Scholar]
- Kowalski, T.; Butin, H. Taxonomie Bekannter Und Neuer Ceratocystis-Arten an Eiche (Quercus robur L.). J. Phytopathol. 1989, 124, 236–248. [Google Scholar] [CrossRef]
- Brilli, F.; Luchi, N.; Michelozzi, M.; Calamai, L.; Cencetti, G.; Pecori, F.; Nigrone, E.; Santini, A. Volatile Organic Compounds (VOC) as Biomarkers for Detection of Ceratocystis platani. For. Pathol. 2020, 50, e12618. [Google Scholar] [CrossRef]
- Kirisits, T.; Krumböck, S.; Konrad, H.; Pennerstorfer, J.; Halmschlager, E. Untersuchungen Über das Auftreten der Erreger der Holländischen Ulmenwelke in Österreich. Forstwiss. Cent. 2001, 120, 231–241. [Google Scholar] [CrossRef]
- Hauptman, T.; Piškur, B.; de Groot, M.; Ogris, N.; Ferlan, M.; Jurc, D. Temperature Effect on Chalara fraxinea: Heat Treatment of Saplings as a Possible Disease Control Method. For. Pathol. 2013, 43, 360–370. [Google Scholar] [CrossRef]
- Brasier, C.M.; Webber, J.F. Is There Evidence for Post-Epidemic Attenuation in the Dutch Elm Disease Pathogen Ophiostoma novo-ulmi? Plant Pathol. 2019, 68, 921–929. [Google Scholar] [CrossRef]
- Fenn, P.; Durbin, R.D.; Kuntz, J.E. Wilt Development in Red Oak Seedlings: A New System for Studying Oak Wilt. Phytopathology 1975, 65, 1381–1386. [Google Scholar] [CrossRef]
- Brasier, C.M.; Webber, J.F. Positive Correlations between in Vitro Growth Rate and Pathogenesis in Ophiostoma Ulmi. Plant Pathol. 1987, 36, 462–466. [Google Scholar] [CrossRef]
- Dickman, M.B. Subversion or Coersion? Pathogenic Determinants in Fungal Phytopathogens. Fungal Biol. Rev. 2007, 21, 125–129. [Google Scholar] [CrossRef]
- Houston, D.R. Importance of Buttress Root and Taphole Wounds as Infection Courts from the Sugar Maple (Acer saccharum) Sapstreak Pathogen, Ceratocystis coerulescens. Phytopathology 1992, 82, 244. [Google Scholar]
- Shigo, A.L. Compartmentalization: A Conceptual Framework for Understanding How Trees Grow and Defend Themselves. Annu. Rev. Phytopathol. 1984, 22, 189–214. [Google Scholar] [CrossRef]
- Shortle, W.C.; Smith, K.T.; Dudzik, K.R.; Parker, S. Response of Maple Sapwood to Injury and Infection. Eur. J. For. Pathol. 1995, 25, 241–252. [Google Scholar] [CrossRef]
- Woodward, S.; Pocock, S. Formation of the Ligno-suberized Barrier Zone and Wound Periderm in Four Species of European Broad-leaved Trees. Eur. J. For. Pathol. 1996, 26, 97–105. [Google Scholar] [CrossRef]
- Dujesiefken, D.; Liese, W.; Shortle, W.; Minocha, R. Response of Beech and Oaks to Wounds Made at Different Times of the Year. Eur. J. For. Res. 2005, 124, 113–117. [Google Scholar] [CrossRef]
- Panconesi, A. Canker Stain of Plane Trees: A Serious Danger to Urban Plantings in Europe. J. Plant Pathol. 1999, 81, 3–15. [Google Scholar]
- Butin, H. Krankheiten der Wald-und Parkbäume. Diagnose-Biologie-Bekämpfung, 2nd ed.; Eugen Ulmer Verlag: Stuttgart, Germany, 2019; ISBN 978-3-8186-0728-9. [Google Scholar]
- Urban, J.; Dvořák, M. Sap Flow-Based Quantitative Indication of Progression of Dutch Elm Disease after Inoculation with Ophiostoma Novo-Ulmi. Trees 2014, 28, 1599–1605. [Google Scholar] [CrossRef]
- Lechner, Y.; Maschek, O.; Kirisits, T.; Halmschlager, E. Further Pathogenicity Testing of Verticillium nonalfalfae, a Biocontrol Agent against the Invasive Tree of Heaven (Ailanthus altissima), on Non-Target Tree Species in Europe. Phytoparasitica 2023, 51, 113–130. [Google Scholar] [CrossRef] [PubMed]
- Soal, N.C.; Coetzee, M.P.A.; van der Nest, M.A.; Hammerbacher, A.; Wingfield, B.D. Phenolic Degradation by Catechol Dioxygenases Is Associated with Pathogenic Fungi with a Necrotrophic Lifestyle in the Ceratocystidaceae. G3 Genes Genomes Genet. 2022, 12, jkac008. [Google Scholar] [CrossRef]
- Smith, K.T.; Houston, D.R. Metal Concentrations in Wood of Sugar Maple Infected with Sapstreak Disease. Can. J. For. Res. 1994, 24, 185–188. [Google Scholar] [CrossRef]
- Kraj, W.; Sztorc, A. Genetic Structure and Variability of Phenological Forms in the European Beech (Fagus sylvatica L.). Ann. For. Sci. 2009, 66, 203. [Google Scholar] [CrossRef]
- Kraj, W. Reactive Oxygen Species and Antioxidant Levels as the Factors of Autumn Senescence in Phenological Forms of Beech (Fagus sylvatica L.). Acta Physiol. Plant. 2016, 38, 32. [Google Scholar] [CrossRef]
- Kraj, W. Antioxidative Enzyme Activity as the Factor Causing Differential Autumn Senescence in Phenological Forms of Beech (Fagus sylvatica L.). Acta Physiol. Plant. 2017, 39, 16. [Google Scholar] [CrossRef]
- Dittmar, C.; Fricke, W.; Elling, W. Impact of Late Frost Events on Radial Growth of Common Beech (Fagus sylvatica L.) in Southern Germany. Eur. J. For. Res. 2006, 125, 249–259. [Google Scholar] [CrossRef]
- Solla, A.; Gil, L. Xylem Vessel Diameter as a Factor in Resistance of Ulmus Minor to Ophiostoma Novo-ulmi. For. Pathol. 2002, 32, 123–134. [Google Scholar] [CrossRef]
- Venturas, M.; López, R.; Martín, J.A.; Gascó, A.; Gil, L. Heritability of Ulmus minor Resistance to Dutch Elm Disease and Its Relationship to Vessel Size, but Not to Xylem Vulnerability to Drought. Plant Pathol. 2014, 63, 500–509. [Google Scholar] [CrossRef]
- Houston, D.R. Spread of the Sugar Maple Sapstreak Disease Pathogen, Ceratocystis coerulescens, via Root Grafts between Acer saccharum. Phytopathology 1991, 81, 122. [Google Scholar]
- Baral, S.K.; Schneider, R.; Pothier, D.; Berninger, F. Predicting Sugar Maple (Acer saccharum) Discoloured Wood Characteristics. Can. J. For. Res. 2013, 43, 649–657. [Google Scholar] [CrossRef]
- Wargo, P.M.; Harrington, T.C. Host Stress and Susceptibility. In Armillaria Root Disease. Agriculture Handbook; Shaw, C.G., Kile, G.A., Eds.; USDA Forest Service: Washington, DC, USA, 1991; Volume 691, pp. 88–101. [Google Scholar]

| Strain * | Origin 1 | Collection Date | Collector 2 | GenBank Accession Numbers | ||
|---|---|---|---|---|---|---|
| 18S-ITS-28S | TUB2 | TEF1 | ||||
| Fs508K * | Rozpucie | 26 August 2021 | PB | PP813732 | PP826203 | PP826220 |
| Fs509K * | Rozpucie | 26 August 2021 | PB | PP813733 | PP826204 | PP826221 |
| Fs510K | Rozpucie | 26 August 2021 | PB | PP813734 | PP826205 | PP826222 |
| Fs511K * | Rozpucie | 26 August 2021 | PB | PP813735 | PP826206 | PP826223 |
| Fs512K | Rozpucie | 26 August 2021 | PB | PP813736 | PP826207 | PP826224 |
| Fs513K | Rozpucie | 26 August 2021 | PB | PP813737 | PP826208 | PP826225 |
| Fs514K | Rozpucie | 26 August 2021 | PB | PP813738 | PP826209 | PP826226 |
| Fs515K | Rozpucie | 26 August 2021 | PB | PP813739 | PP826210 | PP826227 |
| Fs513F * | Ojców | 21 August 2018 | TK | PP813740 | PP826211 | PP826228 |
| Fs514F | Ojców | 21 August 2018 | TK | PP813741 | PP826212 | PP826229 |
| Fs691F | Ojców | 10 October 2018 | TK | PP813742 | PP826213 | PP826230 |
| Fs693F | Ojców | 10 October 2018 | TK | PP813743 | PP826214 | PP826231 |
| Fs694F | Ojców | 10 October 2018 | TK | PP813744 | PP826215 | PP826232 |
| Fs695F | Ojców | 10 October 2018 | TK | PP813745 | PP826216 | PP826233 |
| Fs696F | Ojców | 10 October 2018 | TK | PP813746 | PP826217 | PP826234 |
| Fs697F * | Ojców | 10 October 2018 | TK | PP813747 | PP826218 | PP826235 |
| Fs698F * | Ojców | 10 October 2018 | TK | PP813748 | PP826219 | PP826236 |
| No. of Seedling/ Isolate | Wilting Post Inoculation | Symptoms on Leaves | Length of Bark Necrosis (cm) | Axial Wood Discoloration (cm) | Wood Discoloration, Stem/Roots |
|---|---|---|---|---|---|
| 5/Fs513F | 3 weeks | most of the leaves pale green, occasionally brown, and curled from the edges (Figure 8a) | 1.6 (Figure 8b) | 7.6; grey-brown with darker longitudinal lines (Figure 8c,d) | stem |
| 4/Fs697F | 3 weeks | all leaves greyish-green, slightly wrinkled, curling from the edges (Figure 8e) | 9.6 (Figure 8f) | 16.1; grey-brown with darker longitudinal lines (Figure 8g) or streaks (in upper part) (Figure 8h) | stem |
| 2/Fs508K | 4 weeks | leaves grey-green, brown at the edges, bent, starting to curl at the edges (Figure 8i) | 4.2 (perith. *) | 17.0; grey-brown with darker longitudinal lines (Figure 8j,k) | stem |
| 6/Fs697F | 5 weeks | leaves greyish-green, wrinkled and curled from the edges | 5.8 (Figure 8l) | 7.1; grey-brown with darker longitudinal lines, dark grey in places (Figure 8m,n) | stem |
| 3/Fs509K | 6 weeks | leaves grey-green, wrinkled, some of them curled at the edges | 8.0 (perith. *) | 26.0; grey-brown with darker longitudinal lines (Figure 8o); at the stem base, wood discolored in a striped form (Figure 8p) extending to the roots | stem, roots |
| Isolate Number/Symptom | Length 2 of Wood Discoloration (cm) | Mean (cm) 3,4 | Standard Deviation | Standard Error of Mean | ||||||
|---|---|---|---|---|---|---|---|---|---|---|
| Stem Number | ||||||||||
| 1 | 2 | 3 | 4 | 5 | 6 | |||||
| Fagus sylvatica | ||||||||||
| Fs698F | discol. | 14.5 | 9.6 | 11.8 | 2.6 | 4.6 | 7.7 | 8.47 a | 4.44 | 1.81 |
| necr. | - | - | - | - | - | - | 0.00 A | 0.00 | 0.00 | |
| Fs697F | discol. | 2.6 | 4.1 | 3.2 | 16.1 * | 3.1 | 7.1 * | 6.03 ab | 5.19 | 2.12 |
| necr. | - | 1.8 | - | 9.6 | - | 5.8 | 2.87 A | 3.99 | 1.63 | |
| Fs513F | discol. | 6.4 | 9.1 | 11.4 | 7.8 | 7.6 * | 5.2 | 7.92 a | 2.16 | 0.88 |
| necr. | - | - | 7.2 | - | 1.6 | - | 1.47 A | 2.88 | 1.18 | |
| Fs508K | discol. | 7.8 | 17.0 * | 7.4 | 8.4 | 10.1 | 14.6 | 10.88 a | 3.99 | 1.63 |
| necr. | - | 4.2 | 3.6 | 3.4 | 2.8 | - | 2.33 a | 1.86 | 0.76 | |
| Fs509K | discol. | 8.0 | 9.2 | 26.0 * | 7.8 | 8.5 | 5.5 | 10.83 a | 7.53 | 3.08 |
| necr. | - | - | 8.0 | 1.3 | 1.6 | - | 1.82 A | 3.11 | 1.27 | |
| Fs511K | discol. | 15.6 | 10.4 | 8.3 | 5.1 | 7.0 | 8.4 | 9.13 a | 3.62 | 1.48 |
| necr. | 3.4 | 3.5 | - | 2.3 | - | 1.7 | 1.82 A | 1.56 | 0.64 | |
| control | discol. | 1.4 | 1.1 | 1.3 | 2.2 | 1.7 | 1.3 | 1.50 c | 0.39 | 0.16 |
| necr. | - | - | - | - | - | - | 0.00 A | 0.00 | 0.00 | |
| Acer saccharum | ||||||||||
| Fs698F | discol. | 1.8 | 3.2 | 1.4 | 1.8 | 2.8 | 1.6 | 2.10 bc | 0.72 | 0.30 |
| Fs697F | discol. | 1.6 | 1.3 | 3.0 | 2.2 | 1.4 | 3.3 | 2.13 bc | 0.85 | 0.35 |
| Fs513F | discol. | 1.8 | 1.2 | 3.0 | 1.4 | 3.4 | 1.7 | 2.08 bc | 0.90 | 0.37 |
| Fs508K | discol. | 1.3 | 1.5 | 1.6 | 6.1 | 1.2 | 1.3 | 2.17 c | 1.93 | 0.79 |
| Fs509K | discol. | 2.3 | 1.9 | 5.0 | 1.6 | 1.8 | 4.8 | 2.90 bc | 1.57 | 0.64 |
| Fs511K | discol. | 1.4 | 2.0 | 2.5 | 3.4 | 2.1 | 1.3 | 2.12 bc | 0.77 | 0.32 |
| control | discol. | 1.6 | 0.9 | 1.1 | 1.0 | 1.2 | 1.8 | 1.27 c | 0.36 | 0.15 |
| Site of Sampling of Wood Fragments | Fagus sylvatica | Acer saccharum | ||||
|---|---|---|---|---|---|---|
| With Wilting Symptoms | Without Wilting Symptoms | Number of Wood Fragments Used for Isolation | Number (%) of Wood Fragments Which Yielded D. virescens | |||
| Number of Wood Fragments Used for Isolation | Number (%) of Wood Fragments Which Yielded D. virescens | Number of Wood Fragments Used for Isolation | Number (%) of Wood Fragments Which Yielded D. virescens | |||
| Inoculation wound | 36 | 0 (0.0) | 156 | 15 (9.6) | 150 | 1 (0.7) |
| Zone slightly above and below the wound | 36 | 11 (30.6) | 190 | 18 (9.5) | - | - |
| Lower border of discoloration | 36 | 26 (72.2) | 179 | 41 (22.9) | 215 | 2 (0.9) |
| Upper border of discoloration | 30 | 19 (63.3) | 190 | 62 (32.6) | 219 | 3 (1.4) |
| Total | 138 | 56 (40.6) | 715 | 136 (19.0) | 584 | 6 (1.0) |
| Number (%) of seedlings | 5 | 5 (100.0) | 31 | 26 (83.9) | 36 | 5 (13.9) |
| Number of control seedlings (wood fragments) | - | - | 6 (36) | 0 (0.0) | 6 (36) | 0 (0.0) |
Disclaimer/Publisher’s Note: The statements, opinions and data contained in all publications are solely those of the individual author(s) and contributor(s) and not of MDPI and/or the editor(s). MDPI and/or the editor(s) disclaim responsibility for any injury to people or property resulting from any ideas, methods, instructions or products referred to in the content. |
© 2024 by the authors. Licensee MDPI, Basel, Switzerland. This article is an open access article distributed under the terms and conditions of the Creative Commons Attribution (CC BY) license (https://creativecommons.org/licenses/by/4.0/).
Share and Cite
Kowalski, T.; Bilański, P. Recognition of Davidsoniella virescens on Fagus sylvatica Wood in Poland and Assessment of Its Pathogenicity. J. Fungi 2024, 10, 465. https://doi.org/10.3390/jof10070465
Kowalski T, Bilański P. Recognition of Davidsoniella virescens on Fagus sylvatica Wood in Poland and Assessment of Its Pathogenicity. Journal of Fungi. 2024; 10(7):465. https://doi.org/10.3390/jof10070465
Chicago/Turabian StyleKowalski, Tadeusz, and Piotr Bilański. 2024. "Recognition of Davidsoniella virescens on Fagus sylvatica Wood in Poland and Assessment of Its Pathogenicity" Journal of Fungi 10, no. 7: 465. https://doi.org/10.3390/jof10070465
APA StyleKowalski, T., & Bilański, P. (2024). Recognition of Davidsoniella virescens on Fagus sylvatica Wood in Poland and Assessment of Its Pathogenicity. Journal of Fungi, 10(7), 465. https://doi.org/10.3390/jof10070465

